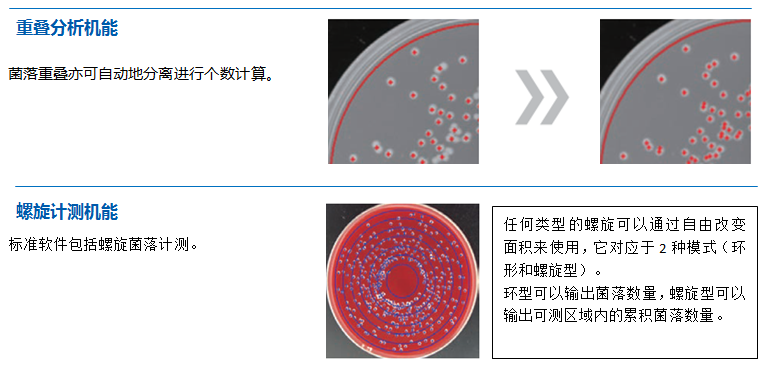
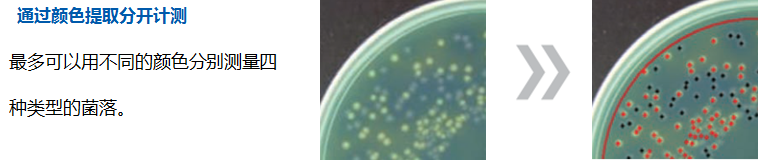

原理:高速图像处理使得操作更加快捷。没有疲劳,它可以让一个人完成更多的样本计测。

原理:每个菌落的面积计算可以单独测量指定的直径。只要培养基厚度固定,它就能够通过固定的二值化系数只测量指定的菌落。

原理:在自动测量时,可以从测量对象中自动排除大的菌落。可测量的区域可自动计算,并可实现精确的CFU转换。



不同数量菌落的计数结果精度



「自动菌落计数仪」特点
---各种菌落数量可以实现高精度计数。

测量结果可以显示或传输到Excel文件
在默认设置下,Petri Dish No,菌落数量和测量区域将显示在软件上。测量结果可以转换为Excel工作表或CSV文件。



「自动菌落计数仪」
--标准软件可以管理圆形、矩形和螺旋形等各种样本。

●软件

全球顶级「自动计测菌落计数仪」--拥有丰富的计测事例。









选配件
抑菌圈计测软件


国初科技(厦门)有限公司
中国·福建·厦门
电话:0592-6518670
传真:0592-6514970
邮箱:info@guochukeji.com
网址:www.guochukeji.com